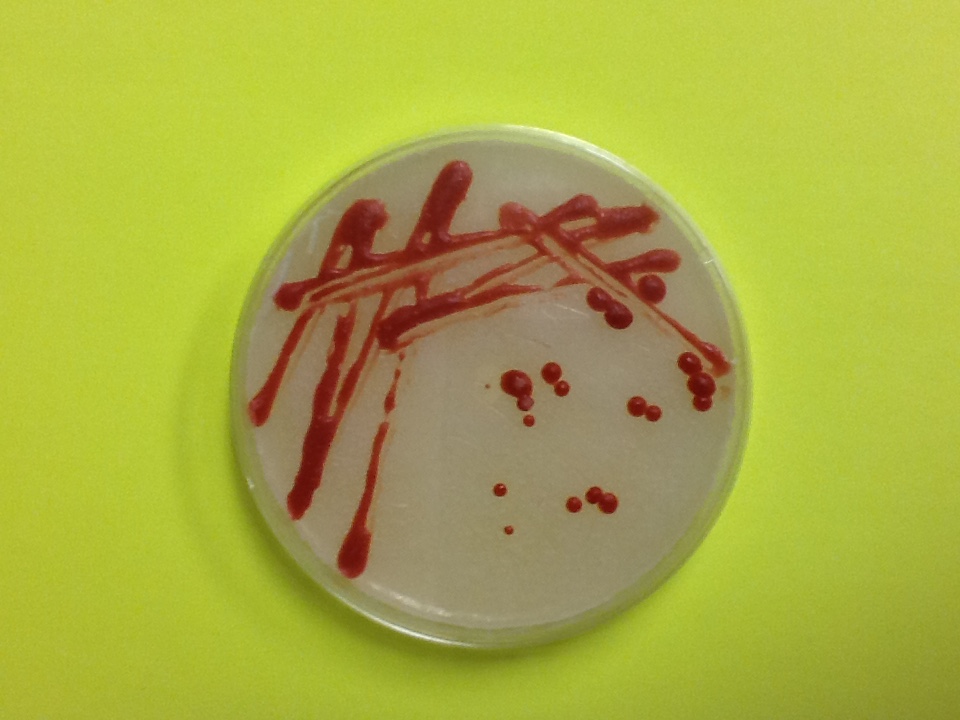
Lab Safety Inspection

Information
-
Jobsite Name
-
Conducted on
-
Prepared by
-
Name of Superintendent
Monthly Fire Extinguisher Inspection
-
undefined
-
Inspected By
-
Fire Extinguisher is mounted in an easily accessible area, with nothing stacked around it.
-
What corrective action will be taken?
-
Discharge Hose/nozzle is in good shape and not clogged, cracked, or broken
-
What corrective action will be taken?
-
Safety Pin is in place and not damaged.
-
What corrective action will be taken?
-
Pressure gauge is in the green, not damaged or showing “recharge”
-
What corrective action will be taken?
-
Label is readable and displays the type of extinguisher and the instructions for use.
-
What corrective action will be taken?
-
Fire Extinguisher is not rusty nor has any type of corrosion build up.
-
What corrective action will be taken?
-
Fire Extinguisher was turned upside down at least three times. (Shaken)
-
What corrective action will be taken?
-
The location of the Fire Extinguisher is easily identifiable. (signs)
-
What corrective action will be taken?
Extension Cord Monthly Inspection
-
Inspected By
Inspection Checklist
-
Power cords and extension cords being used are the proper type and size for the task. Specific cords approved for wet locations are used when necessary.
-
What corrective action will be taken?
-
All extension cords are grounded cords, with the grounding pin intact.
-
What corrective action will be taken?
-
All power cords and extension cords are in good repair, without damage to the outer jacket insulation, plugs, or pins.
-
What corrective action will be taken?
-
Inline or built-in GFCI devices are used when cords are used in wet locations or during construction activities.
-
What corrective action will be taken?
-
Extension cords are used for temporary purposes only, and not as a replacement for permanent building wiring.<br>Extension cords are not zip-tied or otherwise connected to existing conduit or other building features.
-
What corrective action will be taken?
-
Power cords and extension cords are not run through doorways, windows, or unprotected openings or holes in walls.<br>Power
-
What corrective action will be taken?
-
Power cords and extension cords are run so that they do not create tripping hazards.
-
What corrective action will be taken?
-
All equipment with damaged cords have been removed from service.
-
What corrective action will be taken?
-
Any repairs to power cords or extension cords have been made by a qualified person, and the repairs have the same or greater protective qualities as the original cord or plug.
-
What corrective action will be taken?
-
A receptacle tester with GFCI was used to check GFCI breakers, electrical receptacles, and electrical cords for proper wiring.